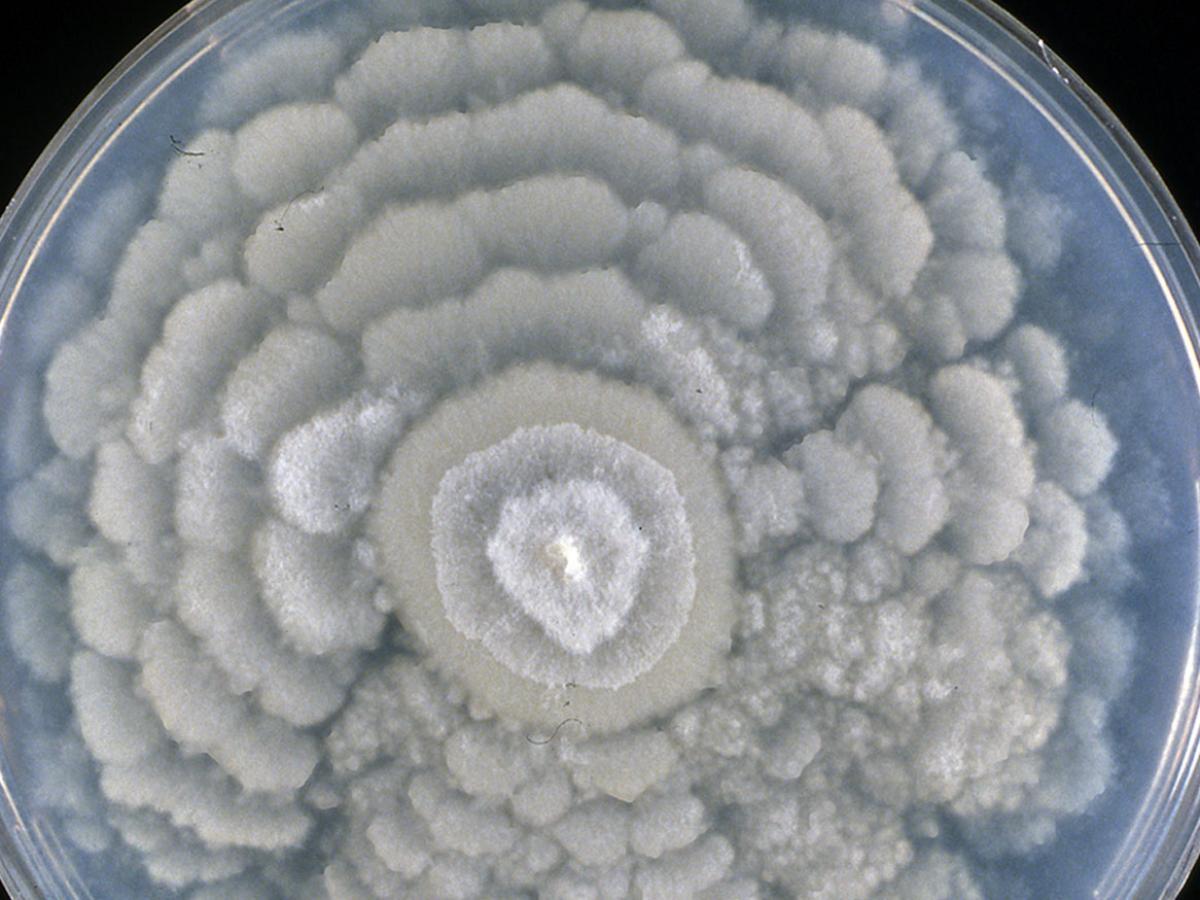
Culture

Unknown 50
Mould identification: a virtual self assessment
Case history
A 7-year-old dairy cow presented with clinical signs of neurologic disease. Despite treatment with penicillin, the cow died 36 hours after initial presentation. Necropsy examination revealed multiple foci of haemorrhage within the cerebrum and thickened meninges. Histology revealed necrotizing vasculitis, infarction, and haemorrhage within sections of the brain, uterus, and lung. Large numbers of intralesional fungal hyphae were visible. The culture below was isolated.
Culture

Microscopy